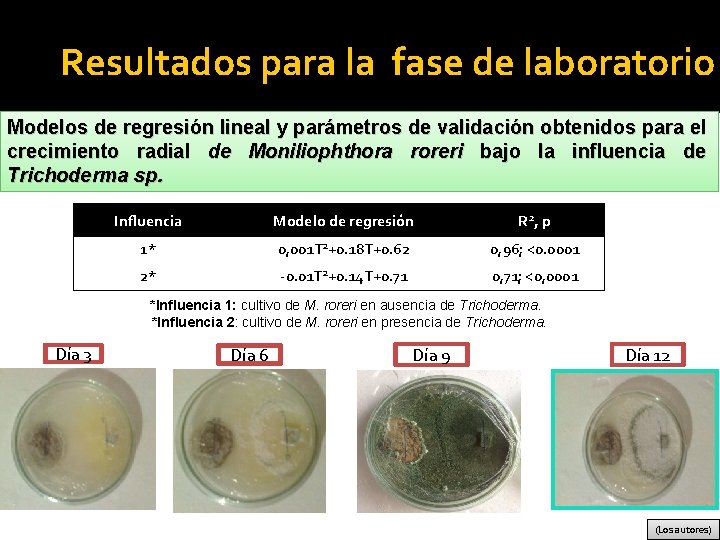
Resultados para la fase de laboratorio Modelos de regresión lineal y parámetros de validación

DEPARTAMENTO DE CIENCIAS DE LA VIDA Y DE

- Slides: 51
DEPARTAMENTO DE CIENCIAS DE LA VIDA Y DE LA AGRICULTURA CARRERA DE INGENIERÍA AGROPECUARIA I. A. S. A. 1 TRABAJO DE TITULACIÓN, PREVIO A LA OBTENCIÓN DEL TÍTULO DE INGENIERO AGROPECUARIO TEMA: “EFECTO DE DIFERENTES COADYUVANTES EN EL ESTABLECIMIENTO Y SUPERVIVENCIA DE TRICHODERMA (Trichoderma sp. ) SOBRE MAZORCAS DE CACAO, PARA EL CONTROL BIOLÓGICO DE LA MONILIASIS (Moniliophthora roreri)” AUTORES: ECHEVERRÍA TAPIA JORGE AURELIO CAMPOS JUCA VIVIANA GABRIELA DIRECTOR: Ing. M. Sc. LANDÁZURI ABARCA PABLO ANÍBAL 2018
Antecedentes isten x e e r o d a Ecu el E En e ha 439. 618 de s a v producti una n o c cacao, edio m o r p n ó i producc 00 3 a de 200 o ñ a / a h / g k (Thomson , 2016) El paí s es el pr produ ctor d imer e cacao fino d e aroma , con m del 70 % de as la produ cción globa l
Antecedentes (ANECACAO, 2016) 2005 2006 2007 2008 2009 2010 2011 2012 2013 2014 2015 2016
Planteamiento del problema e la d a i c n de en la La inci a t n e m u ad a enfermed iosa debido a lluv estación s de e l e v i n s d en los alto a d e m u h d y pluviosida se e d n o d as las zon vo. i t l u c l e a l desarrol La monil ias daños y is causa pér los prod didas a uc hasta el tores , 80 cosecha. % de la (COCNOTICIAS, 2017) s son o t n ie im d n e Los bajos r por provocados mo la o c s e d a enfermed gra y e n a c r o z a monilasis, m. ruja escoba de b
Propuesta de la Investigación han o n s o ic ím ientos qu m a t a r t s ernativa o L lt a a n u o que d a constituido d , le ib n e ni sost osto c u s sustentable y a d es limita n ió c c a u s elevado. (El Productor, 2015) (Los autores) Especies d el género Trichoderma identifican se como anta g onistas de roreri, sin M. embargo, n o existe m información ayor del efecto d e c químicos oadyuvantes sobre la biocontrolad capacidad ora de Tricho derma.
Objetivo general Evaluar el efecto de diferentes coadyuvantes sobre el establecimiento y supervivencia de Trichoderma (Trichoderma sp. ) sobre mazorcas de cacao, para control biológico de la moniliasis (Moniliophthora roreri).
Objetivos específicos Determinar el nivel de antagonismo in vitro entre el controlador biológico Trichoderma sp. y el hongo fitopatógeno Moniliophthora roreri. Determinar la compatibilidad del controlador biológico Trichoderma sp. con diferentes coadyuvantes comerciales para aspersiones agrícolas. Evaluar el efecto, en condiciones de campo, de diferentes coadyuvantes sobre el establecimiento y supervivencia de Trichoderma sp. sobre mazorcas de cacao. Evaluar el efecto, en condiciones de campo, de diferentes coadyuvantes sobre la capacidad antagonista de Trichoderma sp. frente al hongo fitopatógeno Moniliophthora roreri.
Fundamentación teórica Moniliasis del cacao , a s o u ac n e ó i d c i r d pu ad d e , a i m l r Moni , enfe a ceniza a nch a m helad do o o e si v a e c u r o Q do p La mo n por p iliasis del ca ri año 1 mera vez cao fue de en 916, p sc or J. B Ecuador rita en e. Rore l r. dera de la i s n e co origen u f , de dor tes nó o a n r u e t i c n o, E o el ce dios rec se origi d e v Que ños com ero estu medad del siglo a es fer , p l n d a e a cien n i d a , a f rme n que l a i e f b n e stra , Colom (CATIE, 2014) e u m a i e d oqu i t n La enfermedad se en cuentra en todos los en A p a ís es cacaoteros de Sura 18. mérica
Fundamentación teórica cacao l e d s o t los fru a e t n e a solam c a t a d a rmed . La enfe e se u q , o r e tan sev a i de c n s e e u t c n e a r t f s limi s con e e r e o t u c q a a f t Su a e los d o ción. n c u u d a o r r e p d consi a en su i c n a t r o p mayor im (Don Petro, revista electrónica)
Fundamentación teórica i, i, r e r o r a thor h p o i l n i e n d o r M o l de hong h y l e e ) s s e o e t s rfec iliasi e n p o m I m ( m a cete de l l i e d t m n o a r s e u eut ca o c D n e e g s ó a t l pa la c El p e d o ng un ho s. le Monilia (Los autores) (IDIAF, 2018)
CICLO DE VIDA (SENASICA, 2016)
Fundamentación teórica l e d e t par r o n p e a n t e c i t e t dir ral n u i t a o n n ma r recta d i o f d f e n ció ue d a l q q u s p o i v vi s v man e t a l n e s E a ag e d l. d o e r r t b n co hom e c d d a id capac su e s d d o t en m u de a a l s e e o a n óge ovoc t r a p p p n lació ue sobre u p i n ma ataq e Esta m d dad i c a p ca as. plant (ERP, 2016) (LAGE, 2014)
Fundamentación teórica Trichoderma sp. a m r e d icho r T er o n r e e t n r po l gé e s d a s d riza ngo e o t h c a e la. ar d o c s c í e r i e t c g en o a spe t m i e a b s n a m L ple n en el á o d i s han aplicació ia ampl (Los autores) (Agricultura Orgánica, 2012) ado z i l i t u de e t o c n i e alm ol biológ mos p i c n Pri ntr anis os o g c r l o e l o para micr tacan a a otros enos que g pató s vo culti
Fundamentación teórica a d i v e d o l Cic (BIOSIEMBRA, 2014)
Fundamentación teórica Competencia Micoparasitismo Antibiosis Crecimiento quimiotrófico Reconocimiento Adhesión y enrollamiento
Fundamentación teórica Área bajo la curva del progreso de la enfermedad (ABCPE) Se d de eterm i resp incide na a p n a ect o al cia d rtir de e tie mp la gráfic o. o enf erm s o cu rva eda s d con Incidencia de monilia l de a t o t idad t de n a o c d a o l i a de un per d i d e a m ante Es un edad dur m enfer. 40 o tiemp 35 30 25 20 15 10 5 0 20 40 Días 60 80 100
Fundamentación teórica ye u b i r ont c o e d u n q a cu n ica n m ó í i c u co q ac a r i a o c j t n c e Susta r una m a corre a rm realiz en fo la mezc itario. n fitosa a se un (Leiva, 2013) (El Vergel, 2013)
Fundamentación teórica Mecanismo de acción de los coadyuvantes (POLYAGRO, 2015)
Metodología RIO O T A R O B A L E D FASE ü Aislamiento de Moniliophthora roreri y Trichoderma sp. ü Pruebas duales de antagonismo in vitro entre Trichoderma sp. y Moniliophthora roreri ü Pruebas in vitro de compatibilidad de Trichoderma sp. con diferentes coadyuvantes para aspersiones agrícolas.
Metodología Aislamiento del hongo fitopatógeno Moniliophthora roreri. Recolección de mazorcas Vista macroscópica Corte y desinfección Siembra en cajas petri Vista microscópica
Metodología Aislamiento de Trichoderma sp. de suelos cacaoteros, para su utilización en pruebas de antagonismo frente a Moniliophthora roreri. Siembra en cajas Petri Recolección de muestras Vista macroscópica
Metodología Pruebas de antagonismo in vitro entre el controlador biológico Trichoderma sp. y el hongo fitopatógeno Moniliophthora roreri. Variables medidas Procedimiento experimental En una caja Petri con medio PDA se colocó un disco de un cultivo del hongo fitopatógeno, de ser el caso, se sembró a una distancia de 5 cm, un disco de un cultivo de Trichoderma sp. , se dejó en incubación por 12 días a 26°C. Longitud del crecimiento del patógeno sin el antagonista. Longitud del crecimiento del patógeno con el antagonista. PA = [(CR - CRT) / CR] x 100; donde: Porcentaje de Antibiosis de Trichoderma sobre Monilia. PA = Antibiosis (%) CR = Crecimiento radial de M. roreri sin Trichoderma (cm) CRT = Crecimiento radial de M. roreri en presencia de Trichoderma (cm)
Metodología Pruebas in vitro de compatibilidad entre el controlador biológico Trichoderma sp. y diferentes coadyuvantes comerciales para aplicaciones agrícolas. Procedimiento experimental En una caja Petri se dispuso 15 ml del respectivo medio de cultivo, formado por los diferentes tratamientos, sobre este se sembró un disco de cultivo de Trichoderma sp. y se incubó a 26°C durante 12 días. Tratamiento Descripción 1 PDA + Adherente (ECUAFIX® 0, 5 ml. l-1) 2 PDA + Surfactante (SPRAY AIDE® 0, 3 ml. l-1) 3 PDA + Aceite mineral agrícola (COSMO OIL® 10 ml. l-1) 4 PDA
Variables medidas Metodología Longitud del crecimiento de Trichoderma sp. Nivel de esporulación de Trichoderma sp.
Metodología O P M A C E D E S A F Evaluación de los diferentes coadyuvantes sobre el establecimiento y supervivencia de Trichoderma sp. sobre mazorcas de cacao en condiciones de campo.
Metodología Procedimiento experimental A partir del primer día y posteriormente cada 15 días, se contó y eliminó las mazorcas sanas y aquellas con síntomas de moniliasis. Se aplicó los diferentes tratamientos y a partir de la segunda visita se recolectó una mazorca al azar por tratamiento y se la transportó al laboratorio. T 1 Suspensión de Trichoderma en agua (1 x 108 esporas. ml) + Adherente (ECUAFIX® 0. 5 ml. l-1) T 2 Suspensión de Trichoderma en agua (1 x 108 esporas. ml) + Surfactante (SPRAY AIDE® 0. 3 ml. l-1) T 3 Suspensión de Trichoderma en agua (1 x 108 esporas. ml) + Aceite mineral agrícola (COSMO OIL® 10 ml. l-1). T 4 Suspensión de Trichoderma en agua (1 x 108 esporas. ml). T 5 Tratamiento químico convencionalmente usado por el agricultor (PHYTON® 0. 60 ml. l-1) T 6 Testigo
Metodología
Metodología Aplicación de los Tratamientos
Metodología Número de frutos sanos Variables medidas Número de frutos con monilia Porcentaje de Incidencia de monilia Área bajo la curva del progreso de la enfermedad. Establecimiento de Trichoderma sobre mazorcas Supervivencia de Trichoderma sobre mazorcas Cherelles: < 1 mes de edad. Pepinos: 1 a 3 meses de edad. Mazorcas: > 3 meses de edad. Cherelles Wilt: < 1 mes de edad. Chirimoyos: 1 a 3 meses de edad. Mazorcas enfermas: > 3 meses de edad. %IM= (FE/FT) X 100, donde: %IM: % de Incidencia de monilia. FE: Número de frutos enfermos. FT: Número total de frutos.
Resultados para la fase de laboratorio Aislamiento del hongo fitopatógeno Moniliophthora roreri (Los autores) A: Cultivo monospórico de Moniliophthora roreri B, C: Conidias y micelio de Moniliophthora roreri vistas al microscopio (40 x)
Resultados para la fase de laboratorio Micoflora presente en mazorcas de cacao A (Los autores) A: Hifa y esporangios de Phytophthora palmívora vistas al microscopio (40 x). B: Esporas de Colletotrichum gloesporioides vistas al microscopio (40 x). C: Micelio y esporas de Nigrospora sp. vistas al microscopio (40 x).
Resultados para la fase de laboratorio Aislamiento de Trichoderma sp. de suelos cacaoteros Muestreo 1 2 3 Muestra 1 2 3 4 Profundidad (cm. ) 10 15 20 + + + + + + +: Presencia de +: Trichoderma sp.
Resultados para la fase de laboratorio Aislamiento de Trichoderma sp. de suelos cacaoteros. (Los autores) A: Cultivo monospórico de Trichoderma sp. B, C: Fiálides, micelio y esporas de Trichoderma sp. vistas al microscopio (40 x).
Resultados para la fase de laboratorio Pruebas de antagonismo in vitro entre el controlador biológico Trichoderma sp. y el hongo fitopatógeno Moniliophthora roreri. Prueba de Tukey al 5% para el crecimiento radial de Moniliophthora roreri bajo la influencia de Trichoderma sp. (F 1, 8: 170, 04; P<0, 0001) Influencia de Trichoderma sp. Crecimiento radial promedio (cm. ) de Moniliophthora roreri ± E. E. Ausencia* Presencia* 3, 21± 0, 17 a 0, 96± 0, 04 b Promedios con una letra común no son significativamente diferentes (p>0, 05) *Ausencia: cultivo de M. roreri en ausencia de Trichoderma. *Presencia: cultivo de M. roreri en presencia de Trichoderma.
Resultados para la fase de laboratorio Análisis estadístico de la antibiosis de Trichoderma sp. sobre Moniliophthora roreri. D. E: 4, 87 C. V: 6, 99 Antibiosis promedio (%)± E. E. 69, 68± 2, 18 (Los autores)
Resultados para la fase de laboratorio Modelos de regresión lineal y parámetros de validación obtenidos para el crecimiento radial de Moniliophthora roreri bajo la influencia de Trichoderma sp. Influencia Modelo de regresión R 2, p 1* 0, 001 T 2+0. 18 T+0. 62 0, 96; <0. 0001 2* -0. 01 T 2+0. 14 T+0. 71 0, 71; <0, 0001 *Influencia 1: cultivo de M. roreri en ausencia de Trichoderma. *Influencia 2: cultivo de M. roreri en presencia de Trichoderma. Día 3 Día 6 Día 9 Día 12 (Los autores)
Crecimiento radial de Moniliophthora roreri bajo la influencia de Trichoderma sp. con respecto al tiempo. (Los autores) *Ausencia: cultivo de Moniliophthora roreri en ausencia de Trichoderma sp. *Presencia: cultivo de Moniliophthora roreri en presencia de Trichoderma sp.
Resultados para la fase de laboratorio Pruebas in vitro de compatibilidad entre el controlador biológico Trichoderma sp. y diferentes coadyuvantes comerciales para aplicaciones agrícolas. Prueba de Tukey al 5% para el crecimiento radial de Trichoderma sp. sobre medio PDA adicionado con los diferentes coadyuvantes (F 3, 12: 0, 85; p=04929). Tipo de coadyuvante adicionado al medio PDA Surfactante* Aceite agrícola* Adherente* Ninguno* Promedio del Crecimiento radial (cm. ) de Trichoderma sp. ± E. E 4, 47± 0, 03 a 4, 48± 0, 03 a 4, 52± 0, 02 a 4, 54± 0, 05 a Promedios con una letra común no son significativamente diferentes (p>0, 05) * Adherente (ECUAFIX® 0. 5 ml. l-1). * Surfactante (SPRAY AIDE® 0. 3 ml. l-1). * Aceite mineral agrícola (COSMO OIL® 10 ml. l-1). *Ninguno.
Resultados para la fase de laboratorio ANAVA no paramétrico (Kruskall Wallis) al 5% para el nivel de esporulación de Trichoderma sp. sobre medio PDA adicionado con los diferentes coadyuvantes (H 3: 0, 76; p= 0, 7980). Tipo de coadyuvante adicionado al medio PDA Surfactante* Aceite agrícola* Adherente* Ninguno* Nivel de Esporulación de Trichoderma sp. Mediana Rango promedio 2, 50 7, 50 a 3, 00 9, 13 a 3, 00 9, 88 a Rangos promedio con una letra común no son significativamente diferentes (p>0, 05) * Adherente (ECUAFIX® 0. 5 ml. l-1). * Surfactante (SPRAY AIDE® 0. 3 ml. l-1). * Aceite mineral agrícola (COSMO OIL® 10 ml. l-1). * Ninguno.
Resultados para la fase de laboratorio (Los autores)
Resultados para la fase de campo Incidencia de monilia sobre mazorcas asignadas con los diferentes tratamientos. ANAVA no paramétrico (Kruskall Wallis) al 5% para la incidencia de monilia en mazorcas de diferentes edades bajo los diferentes tratamientos. Rangos promedio con una letra común no son significativamente diferentes (p>0, 05) *Adherente: Suspensión de Trichoderma en agua (1 x 108 esporas. ml-1) + Adherente (ECUAFIX® 0. 5 ml. l-1) *Surfactante: Suspensión de Trichoderma en agua (1 x 108 esporas. ml-1) + Surfactante (SPRAY AIDE® 0. 3 ml. l-1) *Aceite agrícola: Suspensión de Trichoderma en agua (1 x 108 esporas. ml-1) + Aceite mineral agrícola (COSMO OIL® 10 ml. l-1) *Sin coadyuvantes: Suspensión de Trichoderma en agua (1 x 108 esporas. ml-1) *Químico: Tratamiento químico convencionalmente usado por el agricultor (PHYTON® 0. 60 ml. l-1) *Testigo: Testigo (ninguna aplicación)
Incidencia total de monilia en función del tiempo para los diferentes tratamientos. 50 45 % Incidencia de monilia 40 35 Adherente* 30 Surfactante* 25 Aceite agrícola* 20 Sin coadyuvantes* 15 Químico* Testigo* 10 5 0 10 20 30 40 50 Días 60 70 80 90 100 *Adherente: Suspensión de Trichoderma en agua (1 x 108 esporas. ml-1) + Adherente (ECUAFIX® 0. 5 ml. l-1) *Surfactante: Suspensión de Trichoderma en agua (1 x 108 esporas. ml-1) + Surfactante (SPRAY AIDE® 0. 3 ml. l 1) *Aceite agrícola: Suspensión de Trichoderma en agua (1 x 108 esporas. ml-1) + Aceite mineral agrícola (COSMO OIL® 10 ml. l-1) *Sin coadyuvantes: Suspensión de Trichoderma en agua (1 x 108 esporas. ml-1) *Químico: Tratamiento químico convencionalmente usado por el agricultor (PHYTON® 0. 60 ml. l-1) *Testigo: Testigo (ninguna aplicación)
Resultados para la fase de campo Área Bajo la Curva del Progreso de la Enfermedad ANAVA no paramétrico (Kruskall Wallis) al 5% para el área bajo la curva del progreso de la enfermedad para los diferentes tratamientos (H 5: 22, 09; p= 0, 0005). Producto aplicado para el control de monilia Aceite agrícola* Sin coadyuvantes* Adherente* Surfactante* Químico* Testigo* Área bajo la curva del progreso de la enfermedad (% incidencia/días) Mediana Rango promedio 462, 61 2, 50 a 657, 08 6, 50 a b 1120, 63 10, 50 a b c 1963, 24 14, 75 b c d 2114, 69 18, 50 c d 2283, 96 22, 25 d Rangos promedio con una letra común no son significativamente diferentes (p>0, 05) *Adherente: Suspensión de Trichoderma en agua (1 x 108 esporas. ml-1) + Adherente (ECUAFIX® 0. 5 ml. l-1) *Surfactante: Suspensión de Trichoderma en agua (1 x 108 esporas. ml-1) + Surfactante (SPRAY AIDE® 0. 3 ml. l 1) *Aceite agrícola: Suspensión de Trichoderma en agua (1 x 108 esporas. ml-1) + Aceite mineral agrícola (COSMO OIL® 10 ml. l-1) *Sin coadyuvantes: Suspensión de Trichoderma en agua (1 x 108 esporas. ml-1) *Químico: Tratamiento químico convencionalmente usado por el agricultor (PHYTON® 0. 60 ml. l-1) *Testigo: Testigo (ninguna aplicación)
Resultados para la fase de campo Establecimiento y Supervivencia de Trichoderma sp. sobre mazorcas de cacao. ANAVA no paramétrico (Kruskall Wallis) al 5% para el porcentaje de establecimiento y supervivencia de Trichoderma sp. sobre mazorcas de cacao bajo los diferentes tratamientos. Rangos promedio con una letra común no son significativamente diferentes (p>0, 05) *Adherente: Suspensión de Trichoderma en agua (1 x 108 esporas. ml-1) + Adherente (ECUAFIX® 0. 5 ml. l-1) *Surfactante: Suspensión de Trichoderma en agua (1 x 108 esporas. ml-1) + Surfactante (SPRAY AIDE® 0. 3 ml. l 1) *Aceite agrícola: Suspensión de Trichoderma en agua (1 x 108 esporas. ml-1) + Aceite mineral agrícola (COSMO OIL® 10 ml. l-1) *Sin coadyuvantes: Suspensión de Trichoderma en agua (1 x 108 esporas. ml-1)
Establecimiento de Trichoderma sobre mazorcas de cacao en función del tiempo. % de Establecimiento de Trichoderma sobre Mazorcas 120 100 80 Adherente* 60 Surfactante* Aceite agrícola* 40 Sin coadyuvantes* 20 15 30 45 60 Tiempo (días) 75 90 *Adherente: Suspensión de Trichoderma en agua (1 x 108 esporas. ml-1) + Adherente (ECUAFIX® 0. 5 ml. l-1) *Surfactante: Suspensión de Trichoderma en agua (1 x 108 esporas. ml-1) + Surfactante (SPRAY AIDE® 0. 3 ml. l-1) *Aceite agrícola: Suspensión de Trichoderma en agua (1 x 108 esporas. ml-1) + Aceite mineral agrícola (COSMO OIL® 10 ml. l -1) *Sin coadyuvantes: Suspensión de Trichoderma en agua (1 x 108 esporas. ml-1)
Crecimiento radial (cm. ) obtenido a 7 días de incubación Supervivencia de Trichoderma sp. (crecimiento radial a 7 días de incubación) sobre mazorcas de cacao en función del tiempo. 3 3 2 Adherente* 2 Surfactante* 1 Aceite agrícola* Sin coadyuvantes* 1 15 30 45 60 Tiempo (días) 75 90 *Adherente: Suspensión de Trichoderma en agua (1 x 108 esporas. ml-1) + Adherente (ECUAFIX® 0. 5 ml. l-1) *Surfactante: Suspensión de Trichoderma en agua (1 x 108 esporas. ml-1) + Surfactante (SPRAY AIDE® 0. 3 ml. l-1) *Aceite agrícola: Suspensión de Trichoderma en agua (1 x 108 esporas. ml-1) + Aceite mineral agrícola (COSMO OIL® 10 ml. l -1) *Sin coadyuvantes: Suspensión de Trichoderma en agua (1 x 108 esporas. ml-1)
Recuperación de Trichoderma sp. a partir de mazorcas sobre las que se aplicó los diferentes tratamientos. (Los autores)
Resultados para la fase de campo Análisis de correlación de Pearson al 5% entre el Porcentaje de establecimiento de Trichoderma sp. , Porcentaje de incidencia de monilia y Supervivencia de Trichoderma sp. sobre mazorcas de cacao. *, *** Significancia al 5, 1 y 0. 01% respectivamente.
CONCLUSIONES sp. y a rm e d o h c ri T e tr n in vitro e o m is n o g ta n a efecto e n d u s e a b rc e je e ru p. p r s a z a li Al rea e Trichoderm u q ó in rm te e d n 70% e u s n e ri o re ll o ro rr a ra s o e d th u h p s Monilio ri, limitando re ro ra o th h p io il n o M antagonista frente a aproximadamente. los y. p s a rm e d o h c ri T itro entre v in d a id il b ti a MO p S O m C o c y e ® d e s id a a b y e ra ru p p Al realizar Ecuafix®, S s la o c rí g a s e n stos e io e rs e d p s a v a ti a ra a ic p if n s ig te s coadyuvan afectación o ia c n e u fl in a n ntró u rma sp. e d o h c ri T e d OIL®, no se enco n ió c o y esporula ll o rr a s e d l e re b o s productos
Conclusiones fix®, a u c E s la o íc r g a ersiones p s a a r a p s y e t ia c n a n v e u iv y v d r a e o p u c s s o cto de l imiento, c le b a t s e l e e Al evaluar el efe a roreri obr r s o h t ® h IL p O io il n O o M M S CO frente a . p s a m r n los Sprayaide® y e o d r o ie h v ic u r t T b o e d e s a t , gonis campo e d s e n io ic d capacidad anta n o ml/l). o, en c 0 a c 1 a ( c ® IL e d O s O a c M r S o rícola CO g sobre maz a e it e c a r a iz il dos al ut a lt u s e r jo e m
Recomendaciones e d n ó i s n e susp a n u e d n r o a i c l o a f d a n n ó o i i 3 - ) adic licac p a m a l c. s a a r 8 d en mo espo o c 0 í 1 s a x , s 1 ( a Se recomi í agua -1 ) cada 15 d n e. p s l. a l ra, b m m 0 o 1 s ( ® e L d I Trichoderm trol O O n M o S c O , C a d a l o o p ra c a e p d s s a e n r u o t r b o aceite agrí a op as l n v i ó i t c c a e z p i l s i t e r r e y f s a m r e f realizar las n 0%. e 1 l s e a d c r r o o z d a e m lred e a d n n e ó i a i c l i o n m o re de m a i c n e d i c n i mantener la